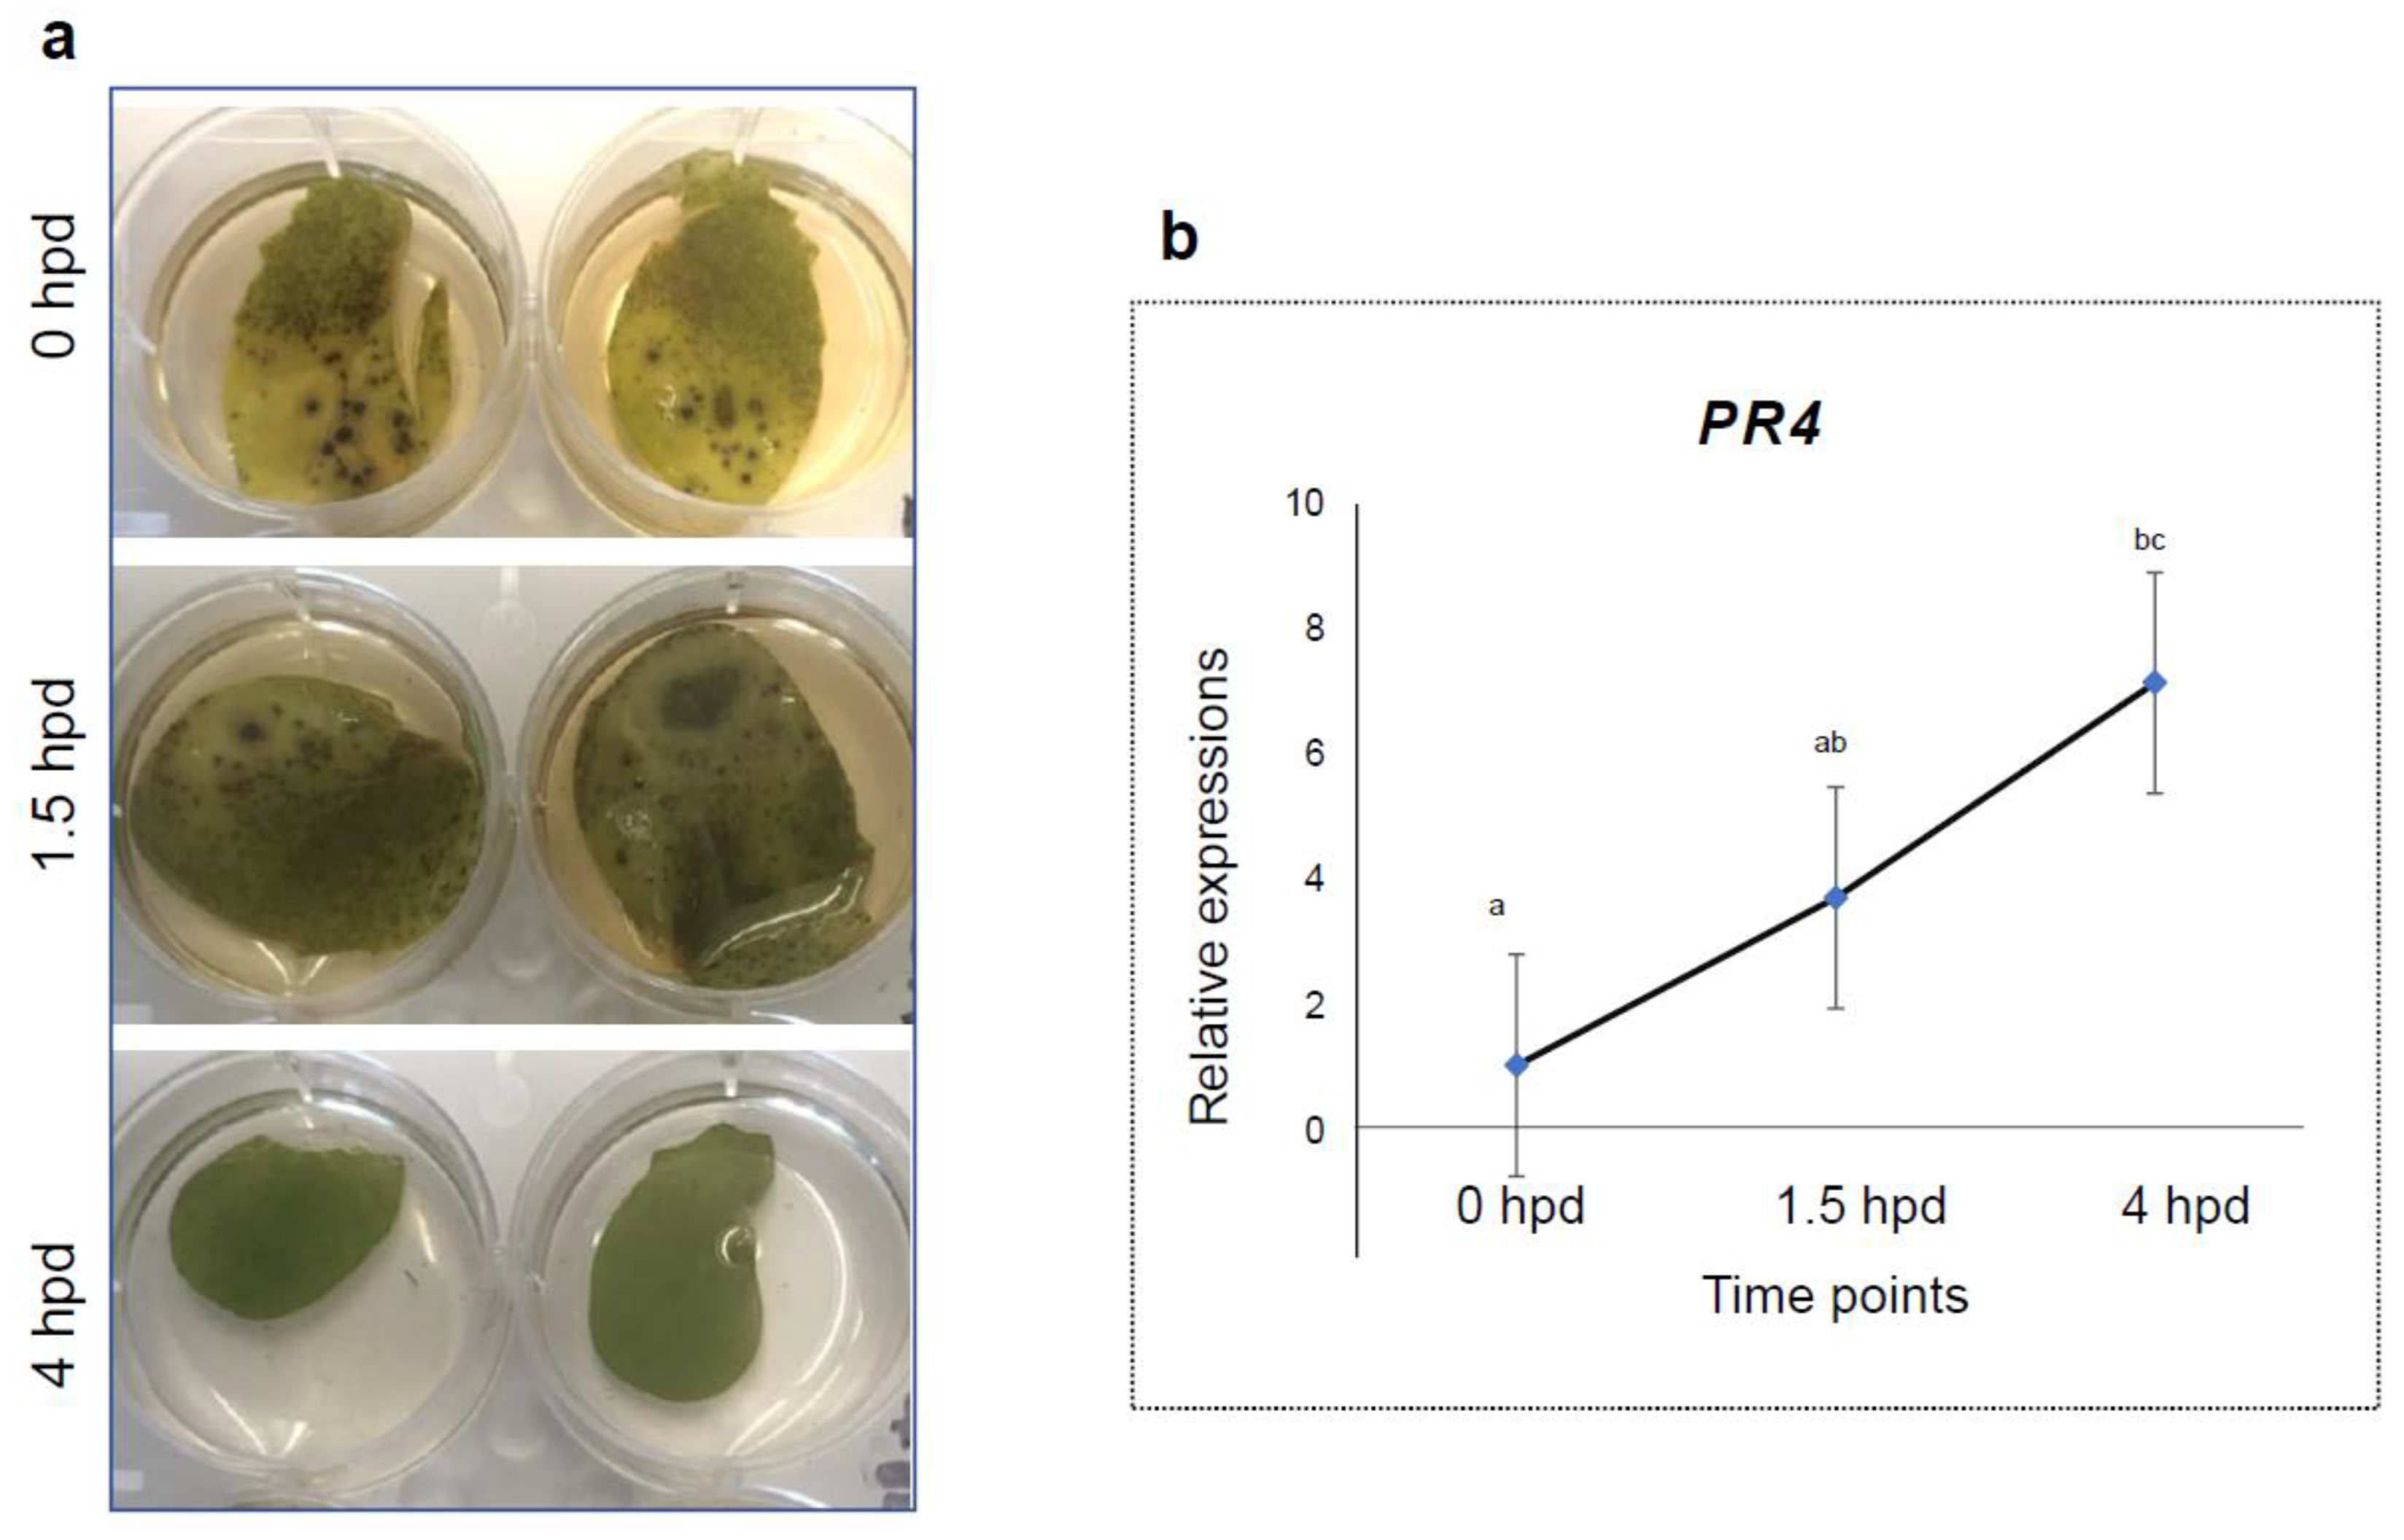
Pathogens 12 00494 g003

Optimized High Throughput Ascochyta Blight Screening Protocols and Immunity to A. pisi in Pea
Abstract
1. Introduction
2. Materials and Methods
2.1. Plant Materials and Growth Conditions
2.2. Pathogens and Growth Conditions
2.3. Inoculum Preparation and Inoculation
2.4. RNA Extraction and PR4 Gene Expression Assay
2.5. Statistical Analysis
3. Results
3.1. Optimization and Comparison of the High Throughput Protocols
3.2. Expression Profiles of PR4 in Detached Leaves
3.3. Different Development Stages Do Not Affect Pea Infection Type to AB
3.4. Host Responses to the Pathogens
4. Discussion
4.1. Optimized Ascochyta Blight Inoculation Protocols
4.2. Different Pathogenicity Factors by Different Species in the Ascochyta Complex
4.3. AB Resistance Breeding in Pea Requires Gene Pyramiding
Author Contributions
Funding
Institutional Review Board Statement
Informed Consent Statement
Data Availability Statement
Conflicts of Interest
References
- Dahl, W.J.; Foster, L.M.; Tyler, R.T. Review of the health benefits of peas (Pisum sativum L.). Br. J. Nutr. 2012, 108 (Suppl. S1), S3–S10. [Google Scholar] [CrossRef] [PubMed]
- Iqbal, A.; Khalil, I.A.; Ateeq, N.; Sayyar Khan, M. Nutritional quality of important food legumes. Food Chem. 2006, 97, 331–335. [Google Scholar] [CrossRef]
- Mudryj, A.N.; Yu, N.; Aukema, H.M. Nutritional and health benefits of pulses. Appl. Physiol. Nutr. Metab. Physiol. Appl. Nutr. Metab. 2014, 39, 1197–1204. [Google Scholar] [CrossRef] [PubMed]
- Field Pea Production. NDSU Agriculture and Extension. 2021. Available online: https://www.ag.ndsu.edu:8000/agriculture/ag-hub/publications/field-pea-production (accessed on 16 July 2022).
- Species Fungorum—Species Synonymy [Internet]. Available online: https://www.speciesfungorum.org/Names/SynSpecies.asp?RecordID=274545 (accessed on 2 March 2023).
- Davidson, J.A.; Hartley, D.; Priest, M.; Herdina, M.K.K.; McKay, A.; Scott, E.S. A new species of Phoma causes ascochyta blight symptoms on field peas (Pisum sativum) in South Australia. Mycologia 2009, 101, 120–128. [Google Scholar] [CrossRef]
- Tivoli, B.; Banniza, S. Comparison of the epidemiology of ascochyta blights on grain legumes. Eur. J. Plant Pathol. 2007, 119, 59–76. [Google Scholar] [CrossRef]
- Bretag, T.W.; Keane, P.J.; Price, T.V.; Bretag, T.W.; Keane, P.J.; Price, T.V. The epidemiology and control of ascochyta blight in field peas: A review. Aust. J. Agric. Res. 2006, 57, 883–902. [Google Scholar] [CrossRef]
- Khan, T.; Timmerman-Vaughan, G.; Rubiales, D.; Warkentin, T.; Siddique, K.; Erskine, W.; Barbetti, M. Didymella pinodes and its management in field pea: Challenges and opportunities. Field Crops Res. 2013, 148, 61–77. [Google Scholar] [CrossRef]
- Owati, A.; Agindotan, B.; Burrows, M. Characterization of Fungal Species Associated with Ascochyta Blight of Dry Pea in Montana and North America and Development of a Differential Medium for Their Detection. Plant Health Prog. 2020, 21, 262–271. [Google Scholar] [CrossRef]
- Barbetti, M.J.; Khan, T.N.; Pritchard, I.; Lamichhane, J.R.; Aubertot, J.-N.; Corrales, D.C.; You, M.P. Challenges with Managing Disease Complexes During Application of Different Measures Against Foliar Diseases of Field Pea. Plant Dis. 2021, 105, 616–627. [Google Scholar] [CrossRef]
- Liu, N.; Xu, S.; Yao, X.; Zhang, G.; Mao, W.; Hu, Q.; Feng, Z.; Gong, Y. Studies on the Control of Ascochyta Blight in Field Peas (Pisum sativum L.) Caused by Ascochyta pinodes in Zhejiang Province, China. Front. Microbiol. 2016, 7, 481. [Google Scholar] [CrossRef]
- Ahmed, H.; Chang, K.-F.; Hwang, S.-F.; Fu, H.; Zhou, Q.; Strelkov, S.; Conner, R.; Gossen, B. Morphological characterization of fungi associated with the ascochyta blight complex and pathogenic variability of Mycosphaerella pinodes on field pea crops in central Alberta. Crops J. 2015, 3, 10–18. [Google Scholar] [CrossRef]
- Kaiser, W.J.; Ramsey, M.D.; Makkouk, K.M.; Bretag, T.W.; Açikgöz, N.; Kumar, J.; Nutter, F.W. Foliar Diseases of Cool Season Food Legumes and Their Control. In Linking Research and Marketing Opportunities for Pulses in the 21st; Current Plant Science and Biotechnology in Agriculture; Knight, R., Ed.; Springer: Dordrecht, The Netherlands, 2000; pp. 1–41. [Google Scholar] [CrossRef]
- McDonald, G.; Peck, D. Effects of crop rotation, residue retention and sowing time on the incidence and survival of ascochyta blight and its effect on grain yield of field peas (Pisum sativum L.). Field Crops Res. 2009, 111, 11–21. [Google Scholar] [CrossRef]
- Karkanis, A.; Ntatsi, G.; Kontopoulou, C.K.; Pristeri, A.; Bilalis, D.; Savvas, D. Field Pea in European Cropping Systems: Adaptability, Biological Nitrogen Fixation and Cultivation Practices. Not. Bot. Horti. Agrobot. Cluj-Napoca 2016, 44, 325–336. [Google Scholar] [CrossRef]
- Davidson, J.A.; Krysinska-Kaczmarek, M.; Wilmshurst, C.J.; McKay, A.; Herdina; Scott, E.S. Distribution and Survival of Ascochyta Blight Pathogens in Field-Pea-Cropping Soils of Australia. Plant Dis. 2011, 95, 1217–1223. [Google Scholar] [CrossRef] [PubMed]
- Chilvers, M.I.; Horton, T.L.; Peever, T.L.; Kaiser, W.J.; Muehlbauer, F.J. First Report of Ascochyta Blight of Pisum elatius (Wild Pea) in the Republic of Georgia Caused by Ascochyta pisi. Plant Dis. 2007, 91, 326. [Google Scholar] [CrossRef]
- Kaiser, W.J.; Viruega, J.R.; Peever, T.L.; Trapero, A. First Report of Ascochyta Blight Outbreak of Pea Caused by Ascochyta pisi in Spain. Plant Dis. 2008, 92, 1365. [Google Scholar] [CrossRef]
- Gossen, B.D.; Hwang, S.F.; Conner, R.L.; Chang, K.F. Managing the Ascochyta Blight Complex on Field Pea in Western Canada. Prairie Soils Crops. 2011, 4, 135–141. [Google Scholar]
- Sivachandra Kumar, N.T.; Banniza, S. Assessment of the Effect of Seed Infection with Ascochyta pisi on Pea in Western Canada. Front. Plant Sci 2017, 8, 933. [Google Scholar] [CrossRef]
- Bahr, L.; Castelli, M.V.; Barolo, M.I.; Mostacero, N.R.; Tosello, M.E.; Lopez, S.N. Ascochyta Blight: Isolation, Characterization, and Development of a Rapid Method to Detect Inhibitors of the Chickpea Fungal Pathogen Ascochyta rabiei. Fungal Biol. 2016, 120, 424–432. [Google Scholar] [CrossRef]
- Gan, Y.T.; Siddique, K.H.M.; MacLeod, W.J.; Jayakumar, P. Management options for minimizing the damage by ascochyta blight (Ascochyta rabiei) in chickpea (Cicer arietinum L.). Field Crops Res. 2006, 97, 121–134. [Google Scholar] [CrossRef]
- Wise, K.A.; Bradley, C.A.; Markell, S.; Pasche, J.; Delgado, J.A.; Goswami, R.S.; Gudmestad, N.C. Sensitivity of Ascochyta rabiei Populations to Prothioconazole and Thiabendazole. Crop Prot. 2011, 30, 1000–1005. [Google Scholar] [CrossRef]
- Clulow, S.A.; Lewis, B.G.; Parker, M.L.; Matthews, P. Infection of pea epicotyls by Mycosphaerella pinodes. Mycol. Res. 1991, 95, 817–820. [Google Scholar] [CrossRef]
- Kraft, J.M.; Dunne, B.; Goulden, D.; Armstrong, S. A Search for Resistance in Peas to Mycosphaerella pinodes. Plant Dis. 1998, 82, 251–253. [Google Scholar] [CrossRef] [PubMed]
- Xue, A.G.; Warkentin, T.D. Partial resistance to Mycosphaerella pinodes in field pea. Can. J. Plant Sci. 2001, 81, 535–540. [Google Scholar]
- Davidson, J.A.; Krysinska-Kaczmarek, M.; AMcKay, H.; Scott, E.S. Comparison of cultural growth and in planta quantification of Didymella pinodes, Phoma koolunga and Phoma medicaginis var. pinodella, causal agents of ascochyta blight on field pea (Pisum sativum). Mycologia 2012, 104, 93–101. [Google Scholar] [CrossRef]
- Fondevilla, S.; ÅVila, C.M.; Cubero, J.I.; Rubiales, D. Response to Mycosphaerella pinodes in a germplasm collection of Pisum spp. Plant Breed. 2005, 124, 313–315. [Google Scholar] [CrossRef]
- Le May, C.; Potage, G.; Andrivon, D.; Tivoli, B.; Outreman, Y. Plant Disease Complex: Antagonism and Synergism Between Pathogens of the Ascochyta Blight Complex on Pea. J. Phytopathol. 2009, 157, 715–721. [Google Scholar] [CrossRef]
- Roger, C.; Tivoli, B. Spatio-temporal development of pycnidia and perithecia and dissemination of spores of Mycosphaerella pinodes on pea (Pisum sativum). Plant Pathol. 1996, 45, 518–528. [Google Scholar] [CrossRef]
- Nyamesorto, B.; Johnson, M.; Gunnink Troth, E.; Parikh, L.P.; Crutcher, F.K.; Owati, A.S.; Agindotan, B.; Burrows, M.E. Development and Applications of Molecular Assays Specific to Ascochyta pisi, Didymella pinodella, and Didymella pinodes Associated with Ascochyta Blight of Dry Pea Seeds; The American Phytopathological Society (APS): St. Paul, MN, USA, 2023. [Google Scholar]
- Die, J.V.; Román, B.; Nadal, S.; González-Verdejo, C.I. Evaluation of candidate reference genes for expression studies in Pisum sativum under different experimental conditions. Planta 2010, 232, 145–153. [Google Scholar] [CrossRef]
- Díaz, J.; ten Have, A.; van Kan, J.A.L. The Role of Ethylene and Wound Signaling in Resistance of Tomato to Botrytis cinerea. Plant Physiol. 2002, 129, 1341–1351. [Google Scholar] [CrossRef]
- Kataria, H.R.; Verma, P.R. Rhizoctonia solani damping-off and root rot in oilseed rape and canola. Crop. Prot. 1992, 11, 8–13. [Google Scholar] [CrossRef]
- Verma, P.R. Biology and control of Rhizoctonia solani on rapeseed: A review. Phytoprotection 1996, 77, 99–111. [Google Scholar] [CrossRef]
- Höhl, B.; Pfautsch, M.; Barz, W. Histology of Disease Development in Resistant and Susceptible Cultivars of Chickpea (Cicer arietinum L.) Inoculated with Spores of Ascochyta rabiei. J. Phytopathol. 1990, 129, 31–45. [Google Scholar] [CrossRef]
- Smith, G.R.; Munro, M.H.G.; Fineran, B.A.; Cole, A.L.J. Evidence for the involvement of ascochitine in Phoma leafspot-wilt disease of Clematis. Physiol. Mol. Plant Pathol. 1994, 45, 333–348. [Google Scholar] [CrossRef]
- Cimmino, A.; Andolfi, A.; Fondevilla, S.; Abouzeid, M.A.; Rubiales, D.; Evidente, A. Pinolide, a new nonenolide produced by Didymella pinodes, the causal agent of ascochyta blight on Pisum sativum. J. Agric. Food Chem. 2012, 60, 5273–5278. [Google Scholar] [CrossRef]
- Evidente, A.; Lanzetta, R.; Capasso, R.; Vurro, M.; Botralico, A. Pinolidoxin, a phytotoxic nonenolide from Ascochyta pinodes. Phytochemistry 1993, 34, 999–1003. [Google Scholar] [CrossRef]
- Kim, W.; Peever, T.L.; Park, J.J.; Park, C.M.; Gang, D.R.; Xian, M.; Davidson, J.A.; Infantino, A.; Kaiser, W.J.; Chen, W. Use of metabolomics for the chemotaxonomy of legume-associated Ascochyta and allied genera. Sci. Rep. 2016, 6, 20192. [Google Scholar] [CrossRef]
- Evidente, A.; Capasso, R.; Andolfi, A.; Vurro, M.; Zonno, M.C. Structure-activity relationship studies of putaminoxins and pinolidoxins: Phytotoxic nonenolides produced by phytopathogenic Phoma and Ascochyta species. Nat. Toxins 1998, 6, 183–188. [Google Scholar] [CrossRef]
- Dixon, R.A.; Achnine, L.; Kota, P.; Liu, C.J.; Reddy, M.S.S.; Wang, L. The phenylpropanoid pathway and plant defence-a genomics perspective. Mol. Plant Pathol. 2002, 3, 371–390. [Google Scholar] [CrossRef]
- Kim, W.; Chen, W. Phytotoxic Metabolites Produced by Legume-Associated Ascochyta and Its Related Genera in the Dothideomycetes. Toxins 2019, 11, 627. [Google Scholar] [CrossRef]
- Fondevilla, S.; Cubero, J.I.; Rubiales, D. Inheritance of resistance to Mycosphaerella pinodes in two wild accessions of Pisum. Eur. J. Plant Pathol. 2007, 119, 53–58. [Google Scholar] [CrossRef]
- Rastogi, K.G.; Saini, S.S. Inheritance of seed shape and resistance to Ascochyta blight in pea (Pisum sativum L.). J. Agric. Sci. 1984, 103, 523–525. [Google Scholar] [CrossRef]

| Name | Sequence | Tm (°C) |
|---|---|---|
| PsPR4F | GCTGGGACTTAAACGCTGTT | 55 |
| PsPR4R | TGTGCTCCTGTCCCTGAATT | 56 |
| PP2AF | CCACATTACCTGTATCGGATGACA | 55 |
| PP2AR | GAGCCCAGAACAGGAGCTAACA | 57 |
Disclaimer/Publisher’s Note: The statements, opinions and data contained in all publications are solely those of the individual author(s) and contributor(s) and not of MDPI and/or the editor(s). MDPI and/or the editor(s) disclaim responsibility for any injury to people or property resulting from any ideas, methods, instructions or products referred to in the content. |
© 2023 by the authors. Licensee MDPI, Basel, Switzerland. This article is an open access article distributed under the terms and conditions of the Creative Commons Attribution (CC BY) license (https://creativecommons.org/licenses/by/4.0/).
Share and Cite
Annan, E.N.; Nyamesorto, B.; Yan, Q.; McPhee, K.; Huang, L. Optimized High Throughput Ascochyta Blight Screening Protocols and Immunity to A. pisi in Pea. Pathogens 2023, 12, 494. https://doi.org/10.3390/pathogens12030494
Annan EN, Nyamesorto B, Yan Q, McPhee K, Huang L. Optimized High Throughput Ascochyta Blight Screening Protocols and Immunity to A. pisi in Pea. Pathogens. 2023; 12(3):494. https://doi.org/10.3390/pathogens12030494
Chicago/Turabian StyleAnnan, Emmanuel N., Bernard Nyamesorto, Qing Yan, Kevin McPhee, and Li Huang. 2023. "Optimized High Throughput Ascochyta Blight Screening Protocols and Immunity to A. pisi in Pea" Pathogens 12, no. 3: 494. https://doi.org/10.3390/pathogens12030494
APA StyleAnnan, E. N., Nyamesorto, B., Yan, Q., McPhee, K., & Huang, L. (2023). Optimized High Throughput Ascochyta Blight Screening Protocols and Immunity to A. pisi in Pea. Pathogens, 12(3), 494. https://doi.org/10.3390/pathogens12030494

